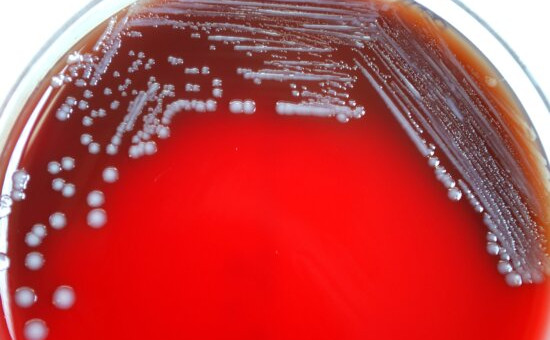

Iznajdljive črevesne bakterije
Dobro jutro! V današnjem Znanstvenem BritOFFu poročamo o raziskavi, ki so jo nedavno objavili v znanstveni reviji Nature. Raziskovalna skupina s Harvarda je namreč ugotovila, da molekula kolibaktin, ki jo izločajo nekatere bakterije v našem črevesju, v sosednjih bakterijah prebudi mirujoče profage.
V mikrobnih združbah, tudi v človeškem mikrobiomu, navadno najdemo polno različnih bioaktivnih naravnih učinkovin, ki jih izločajo bakterije. S temi snovmi bakterije med seboj komunicirajo in tekmujejo, ob čemer lahko vplivajo tudi na človeško počutje. Ena izmed njih je molekula kolibaktin. Pri evkariontih, med katere sodimo tudi ljudje, lahko povzroča navzkrižno povezovanje verig DNK, zaustavitev celičnega cikla in vpliva na nastanek tumorjev pri miših. Kljub dobremu poznavanju njegovega negativnega vpliva na evkarionte, pa je vpliv kolibaktina na okoliške mikrobe v združbi slabše poznan. Prejšnje raziskave so že pokazale, da lahko prisotnost kolibaktina povzroči velike spremembe v sestavi določene mikrobne združbe. V novi študiji pa so podrobneje raziskali vpliv na bakterije.
Najprej so vzeli dva seva Echerichie coli – eden proizvaja kolibaktin, drugi pa ne. Tistega, ki ne proizvaja kolibaktina, so zmešali s supernatantom seva E. coli, ki ga proizvaja. Pri spremljanju viabilnosti bakterij niso opazili nobenih sprememb. Zato so poskusili gojiti oba tipa E. coli skupaj, pri čemer prav tako niso opazili nobenih sprememb v rasti. To pomeni, da kolibaktin očitno do teh bakterij ni bil toksičen. Pri poskusu so namreč uporabili laboratorijske seve, ki v sebi niso imeli mirujočih profagov, zato jih kolibaktin ni mogel aktivirati. Da bi hipotezo o profagih potrdili, so izvedli še poskus, pri katerem so uporabili seve, okužene z mirujočimi profagi.
En sev E. coli so okužili z lambda fagom, torej je sev vseboval dormanten profag, in ponovili eksperiment. Okužene bakterije so gojili s sevom E. coli, ki proizvaja kolibaktin, in s sevom, ki ga ne proizvaja. Po 24 urah so opazili, da je imela kokultura s sevom, ki proizvaja kolibaktin, veliko višje titre fagov kot tista brez kolibaktina. Prav tako so ugotovili, da sproščanje kolibaktina ni odvisno od prisotnosti bakterij, ki imajo v sebi profage. To pomeni, da se je izločal enako močno pri kokulturi z okuženimi ali neokuženimi E. coli. Testiranje so nato razširili na vrste bakterij, ki jih najdemo tudi v človeškem črevesju. Pri vseh bakterijah s profagi so opazili veliko povečanje titra fagov, če so bili izpostavljeni E. coli, ki proizvaja kolibaktin.
Raziskava je ponudila še en vpogled v komunikacijo bakterij v kompleksnih mikrobnih združbah, ki je denimo pri človeškem mikrobiomu pogosto spregledana. Raziskave se namreč navadno osredotočajo na odnose bakterija-človek. Vendar takšen mehanizem kolibaktina lahko močno vpliva na sestavo celotne mikrobne združbe, kar se seveda lahko pozna tudi na človeškem počutju.
S kolibaktinom je bakterije preganjala Dora.

Dodaj komentar
Komentiraj